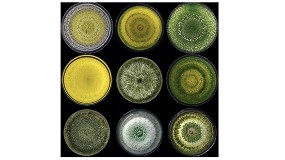

Resultados de la búsqueda "Here"
Costa Blanca se incorpora al circuito internacional UCI HERO Marathon World Cup 2026 - 29/10/2025

HERO Costa Blanca debutará en 2026 como prueba inaugural del circuito UCI HERO Marathon World Cup El arranque de la temporada internacional del circuito HERO de carreras tipo Marathon tendrá
Entrevista a Valentín Albinet, consultor principal en el equipo de Análisis del Mercado Energético de DNV - 08/10/2025

HERO. ¿En qué consiste y qué tipo de análisis permite realizar? HERO (Hybrid Energy Resource Optimizer) es una herramienta web tipo SaaS (Software-as-a-Service) que permite analizar la operación
Microsoft y Vaticano presentan Peter Is Here, un proyecto educativo con Minecraft Educación - 19/03/2025

Here, un proyecto educativo con Minecraft Educación - 19/03/2025: Esta iniciativa de inmersión aúna innovación y tradición en beneficio de estudiantes de todo el mundo Microsoft y Vaticano presentan Peter Is Here
Los olivareros de Adamuz ayudan a las víctimas del accidente de tren - 19/01/2026

heridos, echaron una mano desde el primer momento para auxiliar a las víctimas del accidente. Los olivareros y cooperativistas utilizaron sus todoterrenos para acceder a la zona del siniestro por el camino
Mueble Daily y lavabo Hera de Gala - 28/11/2024

Hera de Gala - 28/11/2024: Mueble Daily y lavabo Hera de Gala Diseñar un baño actual y con personalidad joven pasa por saber elegir un mobiliario funcional, versátil y moderno en su estética
La aplicación de Trichoderma atroviride I-1237 en heridas de poda reduce la infección por hongos asociados al decaimiento por Botryosphaeria - 25/11/2024
heridas de poda reduce la infección por hongos asociados al decaimiento por Botryosphaeria - 25/11/2024: La aplicación de Trichoderma atroviride I-1237 en heridas de poda reduce la infección por hongos
Hero traslada sus retos y logros de sostenibilidad al sector del envase y embalaje - 28/11/2024

Hero traslada sus retos y logros de sostenibilidad al sector del envase y embalaje Hero España , experta en alimentación infantil, mermeladas y snacks saludables, ha presentado sus logros y sus retos
Novedades del sector juguetero para la Campaña de Navidad y Reyes (Parte 3) - 21/10/2025

HAPE TOYNAMICS Audi R8 Fog Maker, de UNICE TOYS (GRUPO MONDO) Kidi DJ Drums, de VTECH Descubre el sistema solar, de BIG MINDS WORLDBRANDS Hero Box Stitch, de YUME TOYS
Entrevista a Alejandro de las Heras, consejero delegado de la Agencia de Ciberseguridad de la Comunidad de Madrid - 16/12/2024

Heras destaca la importancia de estas acciones para consolidar una cultura de ciberseguridad robusta, especialmente en municipios con recursos limitados y sectores críticos como el sanitario. Mariana Morcillo Alejandro de las Heras
GoPro lanza dos nuevas cámaras: HERO13 Black y HERO - 04/09/2024

HERO Black GoPro lanza dos nuevas cámaras: HERO13 Black y HERO GoPro ha anunciado dos nuevas cámaras: la HERO13 Black, con las nuevas e innovadoras lentes HERO Black, y la HERO
Rolser impulsa una nueva forma de vivir la ciudad, más consciente y respetuosa con el entorno - 26/11/2025

héroes de la movilidad urbana por su contribución a un estilo de vida más sostenible, funcional y humano, Rolser , la marca especilaizada en carros de la compra, presenta una iniciativa
Ecoembes y el Ayuntamiento de Logroño refuerzan su estrategia de economía circular - 26/11/2025

Heras; el concejal de Medio Ambiente, Jesús López; y el director de Área Técnica e Innovación de Ecoembes, José Ramírez; en un contexto de impulso normativo y necesidad de mejorar
DIPTRON Argecure: fusión de ciencia y activos naturales para favorecer la cicatrización - 24/10/2025

heridas superficiales, proporciona el mantenimiento y protección de la piel tanto en animales de producción, como el ovino, como en mascotas. Redacción Interempresas La salud cutánea en el ganado ovino
Elf on the Shelf contará con su primer videojuego - 29/08/2025

Heroes. El primer videojuego de Elf on the Shelf, desarrollado por The Lumistella Company y Outright Games, llevará esta popular tradición navideño a las consolas Nintendo Switch, PlayStatin 4, PlayStation
Guiando las carreteras de Europa: la tecnología UV impulsa el próximo capítulo de Buko Infra Support - 08/01/2026

heridas, lo que nos recuerda que cada señal de tráfico, cada advertencia y cada indicador de tráfico desempeña un papel fundamental para garantizar la seguridad de las personas. Para las empresas
La tragedia en Suiza reabre el debate: ¿son seguros los locales de ocio en España? - 08/01/2026

heridas, vuelve a cuestionar la seguridad frente a incendios en los locales de ocio, también en España. Los expertos advierten que cumplir la normativa no garantiza la seguridad y abogan
Novedades de Duravit para 2025 - 14/04/2025

Hero Edition combina el efecto de limpieza profunda con un consumo de agua reducido y un proceso especialmente silencioso. Me by Starck Hero Edition Me by Starck Hero Edition combina
Casamania by Horm revoluciona el diseño exterior con nuevos colores para Him & Her - 28/05/2024

Her - 28/05/2024: El Arte de Fusionar Funcionalidad y Estética: las nuevas propuestas diseñadas por Fabio Novembre Casamania by Horm revoluciona el diseño exterior con nuevos colores para Him & Her La reconocida
Eurosemillas promueve una nueva gran plataforma internacional para consolidar la innovación en la fresa - 26/09/2025

here Eurosemillas se presentará en Fruit Attraction con un expositor en el que el espacio dedicado a presentar The Red Innovation Hub tendrá protagonismo propio. Pero la mayor empresa nacional
Hero Inside se estrena en España en el canal Boing - 15/03/2024

Hero Inside se estrena en España en el canal Boing - 15/03/2024: Hero Inside refuerza su expansión en Europa Hero Inside se estrena en España en el canal Boing Redacción LICENCIAS
